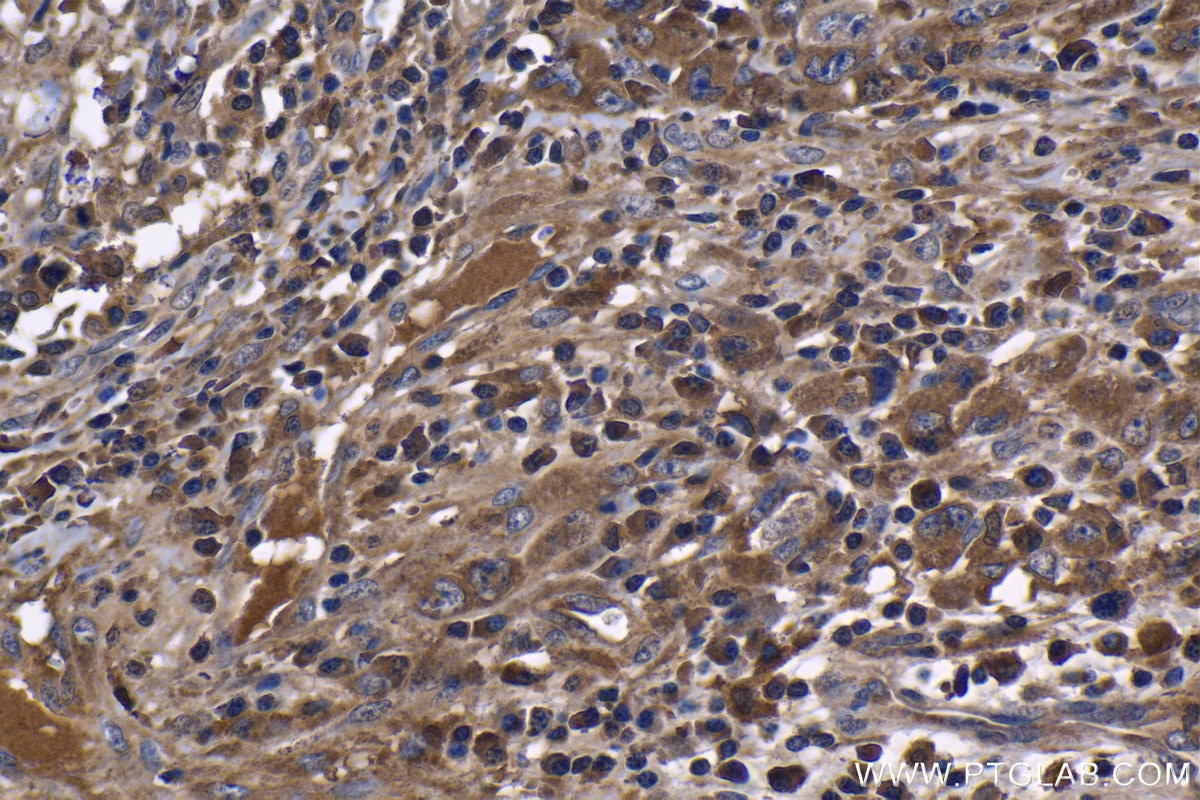
Immunohistochemical analysis of paraffin-embedded human lymphoma tissue slide using 60291-1-Ig (TNF Alpha antibody) at dilution of 1:1000 (under 40x lens). Heat mediated antigen retrieval with Tris-EDTA buffer (pH 9.0). This data was developed using the same antibody clone with 60291-1-PBS in a different storage buffer formulation. Immunohistochemistry (IHC) staining of human lymphoma tissue using TNF-alpha Monoclonal antibody (60291-1-Ig)

Validation Data Gallery
Tested Applications
Recommended dilution
| Application | Dilution |
|---|---|
| It is recommended that this reagent should be titrated in each testing system to obtain optimal results. | |
Product Information
60291-1-PBS targets TNF-alpha in WB, IHC, IF, Indirect ELISA applications and shows reactivity with human, rat samples.
| Tested Reactivity | human, rat |
| Cited Reactivity | human |
| Host / Isotype | Mouse / IgG2b |
| Class | Monoclonal |
| Type | Antibody |
| Immunogen |
CatNo: Ag11413 Product name: Recombinant human TNF-a protein Source: e coli.-derived, PET28a Tag: 6*His Domain: 1-233 aa of BC028148 Sequence: MSTESMIRDVELAEEALPKKTGGPQGSRRCLFLSLFSFLIVAGATTLFCLLHFGVIGPQREEFPRDLSLISPLAQAVRSSSRTPSDKPVAHVVANPQAEGQLQWLNRRANALLANGVELRDNQLVVPSEGLYLIYSQVLFKGQGCPSTHVLLTHTISRIAVSYQTKVNLLSAIKSPCQRETPEGAEAKPWYEPIYLGGVFQLEKGDRLSAEINRPDYLDFAESGQVYFGIIAL 相同性解析による交差性が予測される生物種 |
| Full Name | tumor necrosis factor (TNF superfamily, member 2) |
| Calculated molecular weight | 233 aa, 26 kDa |
| Observed molecular weight | 26 kDa |
| GenBank accession number | BC028148 |
| Gene Symbol | TNF-alpha |
| Gene ID (NCBI) | 7124 |
| ENSEMBL Gene ID | ENSG00000232810 |
| RRID | AB_2833255 |
| Conjugate | Unconjugated |
| Form | |
| Form | Liquid |
| Purification Method | Protein A purification |
| UNIPROT ID | P01375 |
| Storage Buffer | PBS only{{ptg:BufferTemp}}7.3 |
| Storage Conditions | Store at -80°C. |
Background Information
TNF, as also known as TNF-alpha, or cachectin, is a multifunctional proinflammatory cytokine that belongs to the tumor necrosis factor (TNF) superfamily. It is expressed as a 26 kDa membrane bound protein and is then cleaved by TNF-alpha converting enzyme (TACE) to release the soluble 17 kDa monomer, which forms homotrimers in circulation. It is produced chiefly by activated macrophages, although it can be produced by many other cell types such as CD4+ lymphocytes, NK cells, neutrophils, mast cells, eosinophils, and neurons. It can bind to, and thus functions through its receptors TNFRSF1A/TNFR1 and TNFRSF1B/TNFBR. This cytokine is involved in the regulation of a wide spectrum of biological processes including cell proliferation, differentiation, apoptosis, lipid metabolism, and coagulation. This cytokine has been implicated in a variety of diseases, including autoimmune diseases, INS resistance, and cancer.